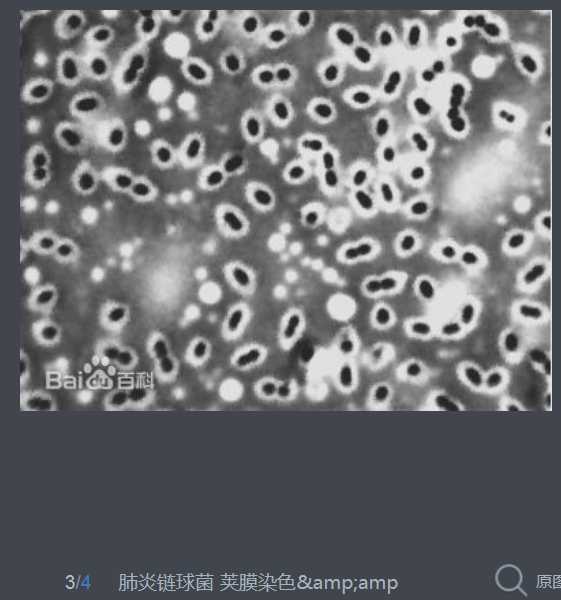
技术分享

肺炎链球菌于1881年首次由巴斯德(Louis Pasteur)及G. M. Sternberg分别在法国及美国从患者痰液中分离出。为革兰染色阳性,菌体似矛头状,成双或成短链状排列的双球菌,有毒株菌体外有化学成分为多糖的荚膜。5%~10%正常人上呼吸道中携带此菌。有毒株是引起人类疾病的重要病原菌。

Streptococcus pneumoniae, or pneumococcus, is a Gram-positive, alpha-hemolytic, facultative anaerobic member of the genus Streptococcus.[1] A significant human pathogenic bacterium, S. pneumoniae was recognized as a major cause of pneumonia in the late 19th century, and is the subject of many humoral immunity studies.
S. pneumoniae resides asymptomatically in the nasopharynx of healthy carriers. The respiratory tract, sinuses, and nasal cavity are the parts of host body that are usually infected. However, in susceptible individuals, such as elderly and immunocompromised people and children, the bacterium may become pathogenic, spread to other locations and cause disease. S. pneumoniae is the main cause of community acquired pneumonia and meningitis in children and the elderly, and of septicemia in HIV-infected persons. The methods of transmission include sneezing, coughing, and direct contact with an infected person.
Despite the name, the organism causes many types of pneumococcal infections other than pneumonia. These invasive pneumococcal diseases include bronchitis, rhinitis, acute sinusitis, otitis media, conjunctivitis, meningitis, bacteremia, sepsis, osteomyelitis, septic arthritis, endocarditis, peritonitis, pericarditis, cellulitis, and brain abscess.[2]
S. pneumoniae is one of the most common causes of bacterial meningitis in adults and young adults, along with Neisseria meningitidis, and is the leading cause of bacterial meningitis in adults in the USA. It is also one of the top two isolates found in ear infection, otitis media.[3] Pneumococcal pneumonia is more common in the very young and the very old. It also is a major bacterium for invasive diseases like pneumonia and meningitis in South Asian children 12 years of age, though the evidence is of low quality and scarce.[4]
S. pneumoniae can be differentiated from Streptococcus viridans, some of which are also alpha-hemolytic, using an optochin test, as S. pneumoniae is optochin-sensitive. S. pneumoniae can also be distinguished based on its sensitivity to lysis by bile, the so-called "bile solubility test". The encapsulated, Gram-positive coccoid bacteria have a distinctive morphology on Gram stain, lancet-shaped diplococci. They have a polysaccharide capsule that acts as a virulence factor for the organism; more than 90 different serotypes are known, and these types differ in virulence, prevalence, and extent of drug resistance.
In 1881, the organism, known as the pneumococcus for its role as an [etiologic agent] of pneumonia, was first isolated simultaneously and independently by the U.S. Army physician George Sternberg[5] and the French chemist Louis Pasteur.[6]
The organism was termed Diplococcus pneumoniae from 1920[7] because of its characteristic appearance in Gram-stained sputum. It was renamed Streptococcus pneumoniae in 1974 because of its growth in chains in liquid growth media.
S. pneumoniae played a central role in demonstrating genetic material consists of DNA. In 1928, Frederick Griffith demonstrated transformation of life, turning harmless pneumococcus into a lethal form by co-inoculating the live pneumococci into a mouse along with heat-killed, virulent pneumococci.[8] In 1944, Oswald Avery, Colin MacLeod, and Maclyn McCarty demonstrated the transforming factor in Griffith‘s experiment was DNA, not protein, as was widely believed at the time.[9] Avery‘s work marked the birth of the molecular era of genetics.[10]
The genome of S. pneumoniae is a closed, circular DNA structure that contains between 2.0 and 2.1 million base pairs, depending on the strain. It has a core set of 1553 genes, plus 154 genes in its virulome, which contribute to virulence, and 176 genes that maintain a noninvasive phenotype. Genetic information can vary up to 10% between strains.[11]
Natural bacterial transformation involves the transfer of DNA from one bacterium to another through the surrounding medium. Transformation is a complex, developmental process requiring energy, dependent on expression of numerous genes. In S. pneumoniae at least 23 genes are required. In order for a bacterium to bind, take up and recombine exogenous DNA into its chromosome it must enter a special physiological state, called competence.
Competence, in S. pneumoniae, is induced by DNA-damaging agents such as mitomycin C, a DNA inter-strand cross-linking agent, and the fluoroquinolone antibiotics norfloxacin, levofloxacin and moxifloxacin, topoisomerase inhibitors that cause double-strand breaks.[12] Transformation protects S. pneumoniae against the bactericidal effect of mitomycin C.[13] Michod et al.[14] summarized evidence that induction of competence in S. pneumoniae is associated with increased resistance to oxidative stress and increased expression of the RecA protein, a key component of the recombinational repair machinery for removing DNA damages. On the basis of these findings, they suggested that transformation is an adaptation for repairing oxidative DNA damages. S. pneumoniae infection stimulates polymorphonuclear leukocytes (granulocyte) to produce an oxidative burst that is potentially lethal to the bacteria. The ability of S. pneumoniae to repair the oxidative DNA damages in its genome, caused by this host defense, likely contributes to this pathogen’s virulence.
S. pneumoniae is part of the normal upper respiratory tract flora, but, as with many natural flora, it can become pathogenic under the right conditions, like if the immune system of the host is suppressed. Invasins, such as pneumolysin, an anti-phagocytic capsule, various adhesins and immunogenic cell wall components are all major virulence factors.
Both Haemophilus influenzae (H. influenzae) and S. pneumoniae can be found in the human upper respiratory system. A study of competition in vitro revealed S. pneumoniae overpowered H. influenzae by attacking it with hydrogen peroxide.[15]
When both bacteria are placed together into the nasal cavity of a mouse, within 2 weeks, only H. influenzae survives. When both are placed separately into a nasal cavity, each one survives. Upon examining the upper respiratory tissue from mice exposed to both bacteria, an extraordinarily large number of neutrophil immune cells were found. In mice exposed to only one bacterium, the cells were not present.
Lab tests show neutrophils that were exposed to already-dead H. influenzae were more aggressive in attacking S. pneumoniae than unexposed neutrophils. Exposure to killed H. influenzae had no effect on live H. influenzae.
Two scenarios may be responsible for this response:
It is unclear why H. influenzae is not affected by the immune system response.[16]
Diagnosis is generally made based on clinical suspicion along with a positive culture from a sample from virtually any place in the body. An ASO Titre of >200 units is significant.[2] S. pneumoniae is, in general, optochin sensitive, although optochin resistance has been observed.[17]
Atromentin and leucomelone possess antibacterial activity, inhibiting the enzyme enoyl-acyl carrier protein reductase, (essential for the biosynthesis of fatty acids) in S. pneumoniae.[18]
原文:http://www.cnblogs.com/biopy/p/4563148.html